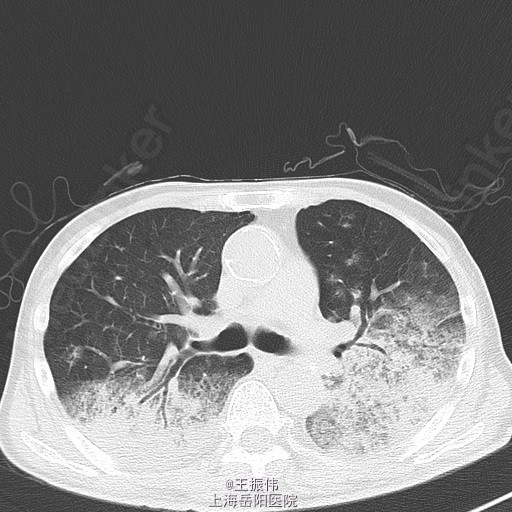

反复咳嗽咳痰气促3年,加重伴发热8日,患者3年前因咳嗽咳痰、气促至中山医院就诊,诊断为“肺部恶性肿瘤”,予手术治疗,具体诊疗过程不详。之后患者长期口服特罗凯、吉诺通等药物,仍时有咳嗽咳痰。8日前患者无明显诱因下出现发热,T最高:38.5℃,咳嗽咳痰、气促加重,夜间尤甚,咳白色泡沫痰,量多。至我院急诊就诊,查CRP:34.95mg/L,血常规:WBC10.3*10^9/L,N79%,予邦达抗感染治疗后,患者热退,仍时有咳嗽咳痰,2日前再次发热,T:38.5℃,复查CRP:24.09mg/L,血常规:WBC8.4*10^9/L,N77%,
气管居中,颈静脉正常,胸廓两侧对称,无桶状胸,呼吸运动两侧对称,呼吸频率24次/分,肋间隙正常,无胸膜摩擦感。两肺叩诊可及清音,两肺有湿性啰音,(7.17 岳阳医院)CRP:24.09mg/L,血常规:WBC8.4*10^9/L,N77%。(7.19)[胸部CT,平扫](21516866)1.结合病史,左肺术后;两肺炎症,请治疗后复查。2.右侧胸腔积液,双侧胸膜增厚。3.主动脉及冠脉血管壁钙化。4.甲状腺右叶低密度影,请进一步检查。请结合增强检查。癌胚抗原CEA:27.97;糖类抗原CA199:大于 700;细胞角蛋白19片段(CYFRA21-1):8.6630;糖类抗原CA-50:大于500;糖类抗原CA242:大于200;SCC鳞癌相关抗原:4.629ng/ml

肺癌型肺炎,予邦达、可乐必妥抗感染,多索茶碱、阿斯美解痉平喘,兰苏、吉诺通化痰
肺癌是发病率和死亡率增长最快,对人群健康和生命威胁最大的恶性肿瘤之一。男性肺癌发病率和死亡率均占所有恶性肿瘤的第一位,女性发病率占第二位,死亡率占第二位。肺癌的病因至今尚不完全明确,大量资料表明,长期大量吸烟与肺癌的发生有非常密切的关系。